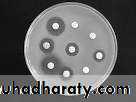

Types of culture media
According to physical statusSolid culture media (agar)
Liquid media (broth)
Semisolid (used for testing of motility).
According to use
Simple culture media e.g. nutrient agar and nutrient brothUse for isolation of non fastidious mo
nutrient agar
Enriched media the nutrient substance in this media is increased by the addition of substances such as blood, serum glucose or other substance, e.g. blood agar and chocolate agar. It is usually used for primary isolation of all mo and culture of fastidious mo
blood agar enriched by 5% sheep blood
chocolate agar (heated blood agar) heating of blood will caused destruction and releasing of the nutrient substances in the RBC and increase enrichments
Selective culture media the addition of inhibitory substances to the culture media make it selective which allow the growth of certain mo and inhibit the growth of others, e.g. Mannitol salt agar MacConkey agar. The inhibitory substances such as bile salt, high salt content.
MSA selective for Staph
MacConkey agar selective for gram negative bacilli
Differential media it allows the differentiation between different mo by the changes of media from state to other as color changes or formation of clear zone as in blood agar or the difference in the color of colonies , eg Mannitol salt agar differentiate spp of Staphylococci.
blood agar differentiate between haemolytic and non haemolytic mo.
Mac Conkey agar between lactose fermentor and non lactose fermentor
Some culture media have to function
Selective and differential MSA
Enriched and differential blood agar
MacConkeys agar Selective and differential
Selective for gram negative and diffential differentiated between lactose fermentor and lactose fermentor
Antibiotic susceptibility testing
This test is done to know the appropriate antimicrobial agents to be used for the treatment of the causative bacteria.
Disk diffusion test
The culture media inoculated by the pathogenic bacteria and a paper discs impregnated by different type of antibiotic
(Each disc for specific antimicrobial agent eg disc for ampicillin and other for gentamicin, amikacin rifampicin …etc) are placed on this culture media. The culture is incubated at 37 C for 24-48 hr according to the type of mo. The test results are red as the followings:
A Zone of inhibition of growth (no growth around the disc) the bacteria is sensitive to this agent.
If the growth of mo reached the edge of the disc this mo is resistant to this antimicrobial drug.
No zone of inhibition
Growth to the edge of the disc
resistant
Zone of inhibition
No growthsensitive